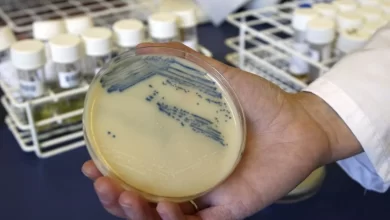
المقاومة للمضادات الحيوية

صحة
-

ثورة طبية ستغير وجه العالم.. روسيا تقترب من إطلاق أول لقاح ثوري لعلاج السرطان
وطن – أعلنت روسيا عن قرب اعتماد لقاح ثوري مضاد للسرطان، يعد الأول من نوعه عالميًا. يعتمد اللقاح على تقنية…
-
باحثون يحذرون من أن الجراثيم المقاومة للأدوية ستقتل ملايين البشر في العقود المقبلة
وطن – منذ بداية عصر المضادات الحيوية، تطورت البكتيريا والجراثيم المسببة للأمراض بسرعة، مما جعلها قادرة على مقاومة الأدوية التي…
-

ارتفاع حالات تسمم الأطفال بمشروبات الطاقة: مراكز السموم الأمريكية تحذر من المخاطر المتزايدة
وطن – تشهد مراكز السموم الأمريكية زيادة مقلقة في عدد المكالمات المتعلقة بالأطفال الذين يستهلكون مشروبات الطاقة. وفقًا لأحدث البيانات،…
-
![تم الآن كشف لغز فصيلة الدم بعد عقود من الزمان [NHS Blood and Transplant]](https://www.watanserb.com/wp-content/uploads/2024/09/تم-الآن-كشف-لغز-فصيلة-الدم-بعد-عقود-من-الزمان-NHS-Blood-and-Transplant--390x220.webp)
علماء يكتشفون فصيلة دم جديدة بعد غموض استمر 50 عامًا
وطن – في إنجاز طبي قد ينقذ حياة الآلاف حول العالم، تمكن علماء من هيئة الخدمات الصحية الوطنية البريطانية (NHS)…
-

تم استخدامه كمصدر للشفاء لمدة 5 آلاف سنة!.. الشاي المعجزة الذي يجعل العظام قوية كالحديد
وطن – الهند، بلد التوابل والعجائب، تشتهر بمشروباتها التقليدية التي ليست فقط لذيذة بل مفيدة للصحة. شاي ماسالا، الذي يُستهلك…
-

ما قصة “العلكة” التي شغلت “تيك توك” وتساعد في تحسين الفك؟
وطن – يقول المؤثرون على وسائل التواصل الاجتماعي إن مضغ العلكة الصلبة ساعد في تحديد خطوط الفك لديهم بشكل أكثر…
-

شرب هذا العدد من أكواب القهوة يوميًا قد يعرض صحة قلبك للخطر
وطن – توصلت دراسة بحثية جديدة إلى أن شرب أكثر من 400 مليجرام من الكافيين بشكل مستمر كل يوم قد…
-

خبر يهم كل نساء الأرض: اعتماد صور الأشعة السينية لكشف سرطان الثدي مبكراً وبشكل دقيق
وطن – يعاني ما يقرب من نصف النساء فوق سن الأربعين من ما يعتبره الأطباء أنسجة ثدي كثيفة، مما يزيد…
-

إلى كل من يعاني من قلة النوم: كيف تتخلص من الأرق بطرق بسيطة وفعّالة
وطن – إذا كنت تعاني من الأرق وعدم القدرة على النوم بسبب الضغوط والصراعات اليومية، فأنت لست وحدك. السبب الرئيسي…
-

مع دخول العيد وتغير النظام الغذائي.. أطعمة قد تسبب السكتات الدماغية احذر تناولها
وطن – السكتات الدماغية تحدث عندما يكون تدفق الدم إلى الدماغ مقيدا أو مسدودا، وعادة ما يكون ذلك بسبب جلطة…
